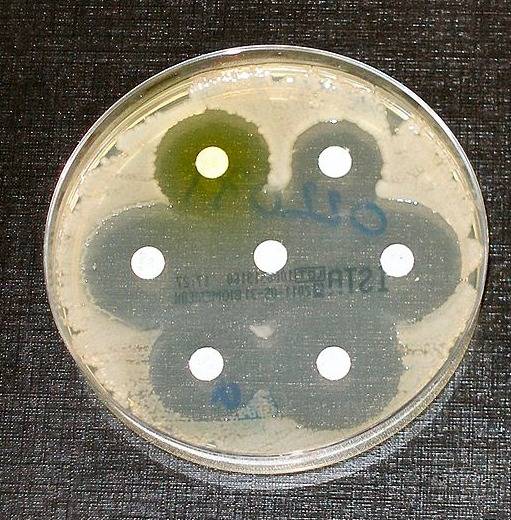

Democracy under threat: The autumn New Humanist
Out now – featuring Peter Geoghegan on the US funders of European hate, Kaya Genç on Turkey’s Covid-19 clampdown and Ting Guo on divide and rule in Hong Kong.











Join Humanists UK and help us support lasting change for a better society and a tolerant world where rational thinking and kindness prevail. Why not join today?